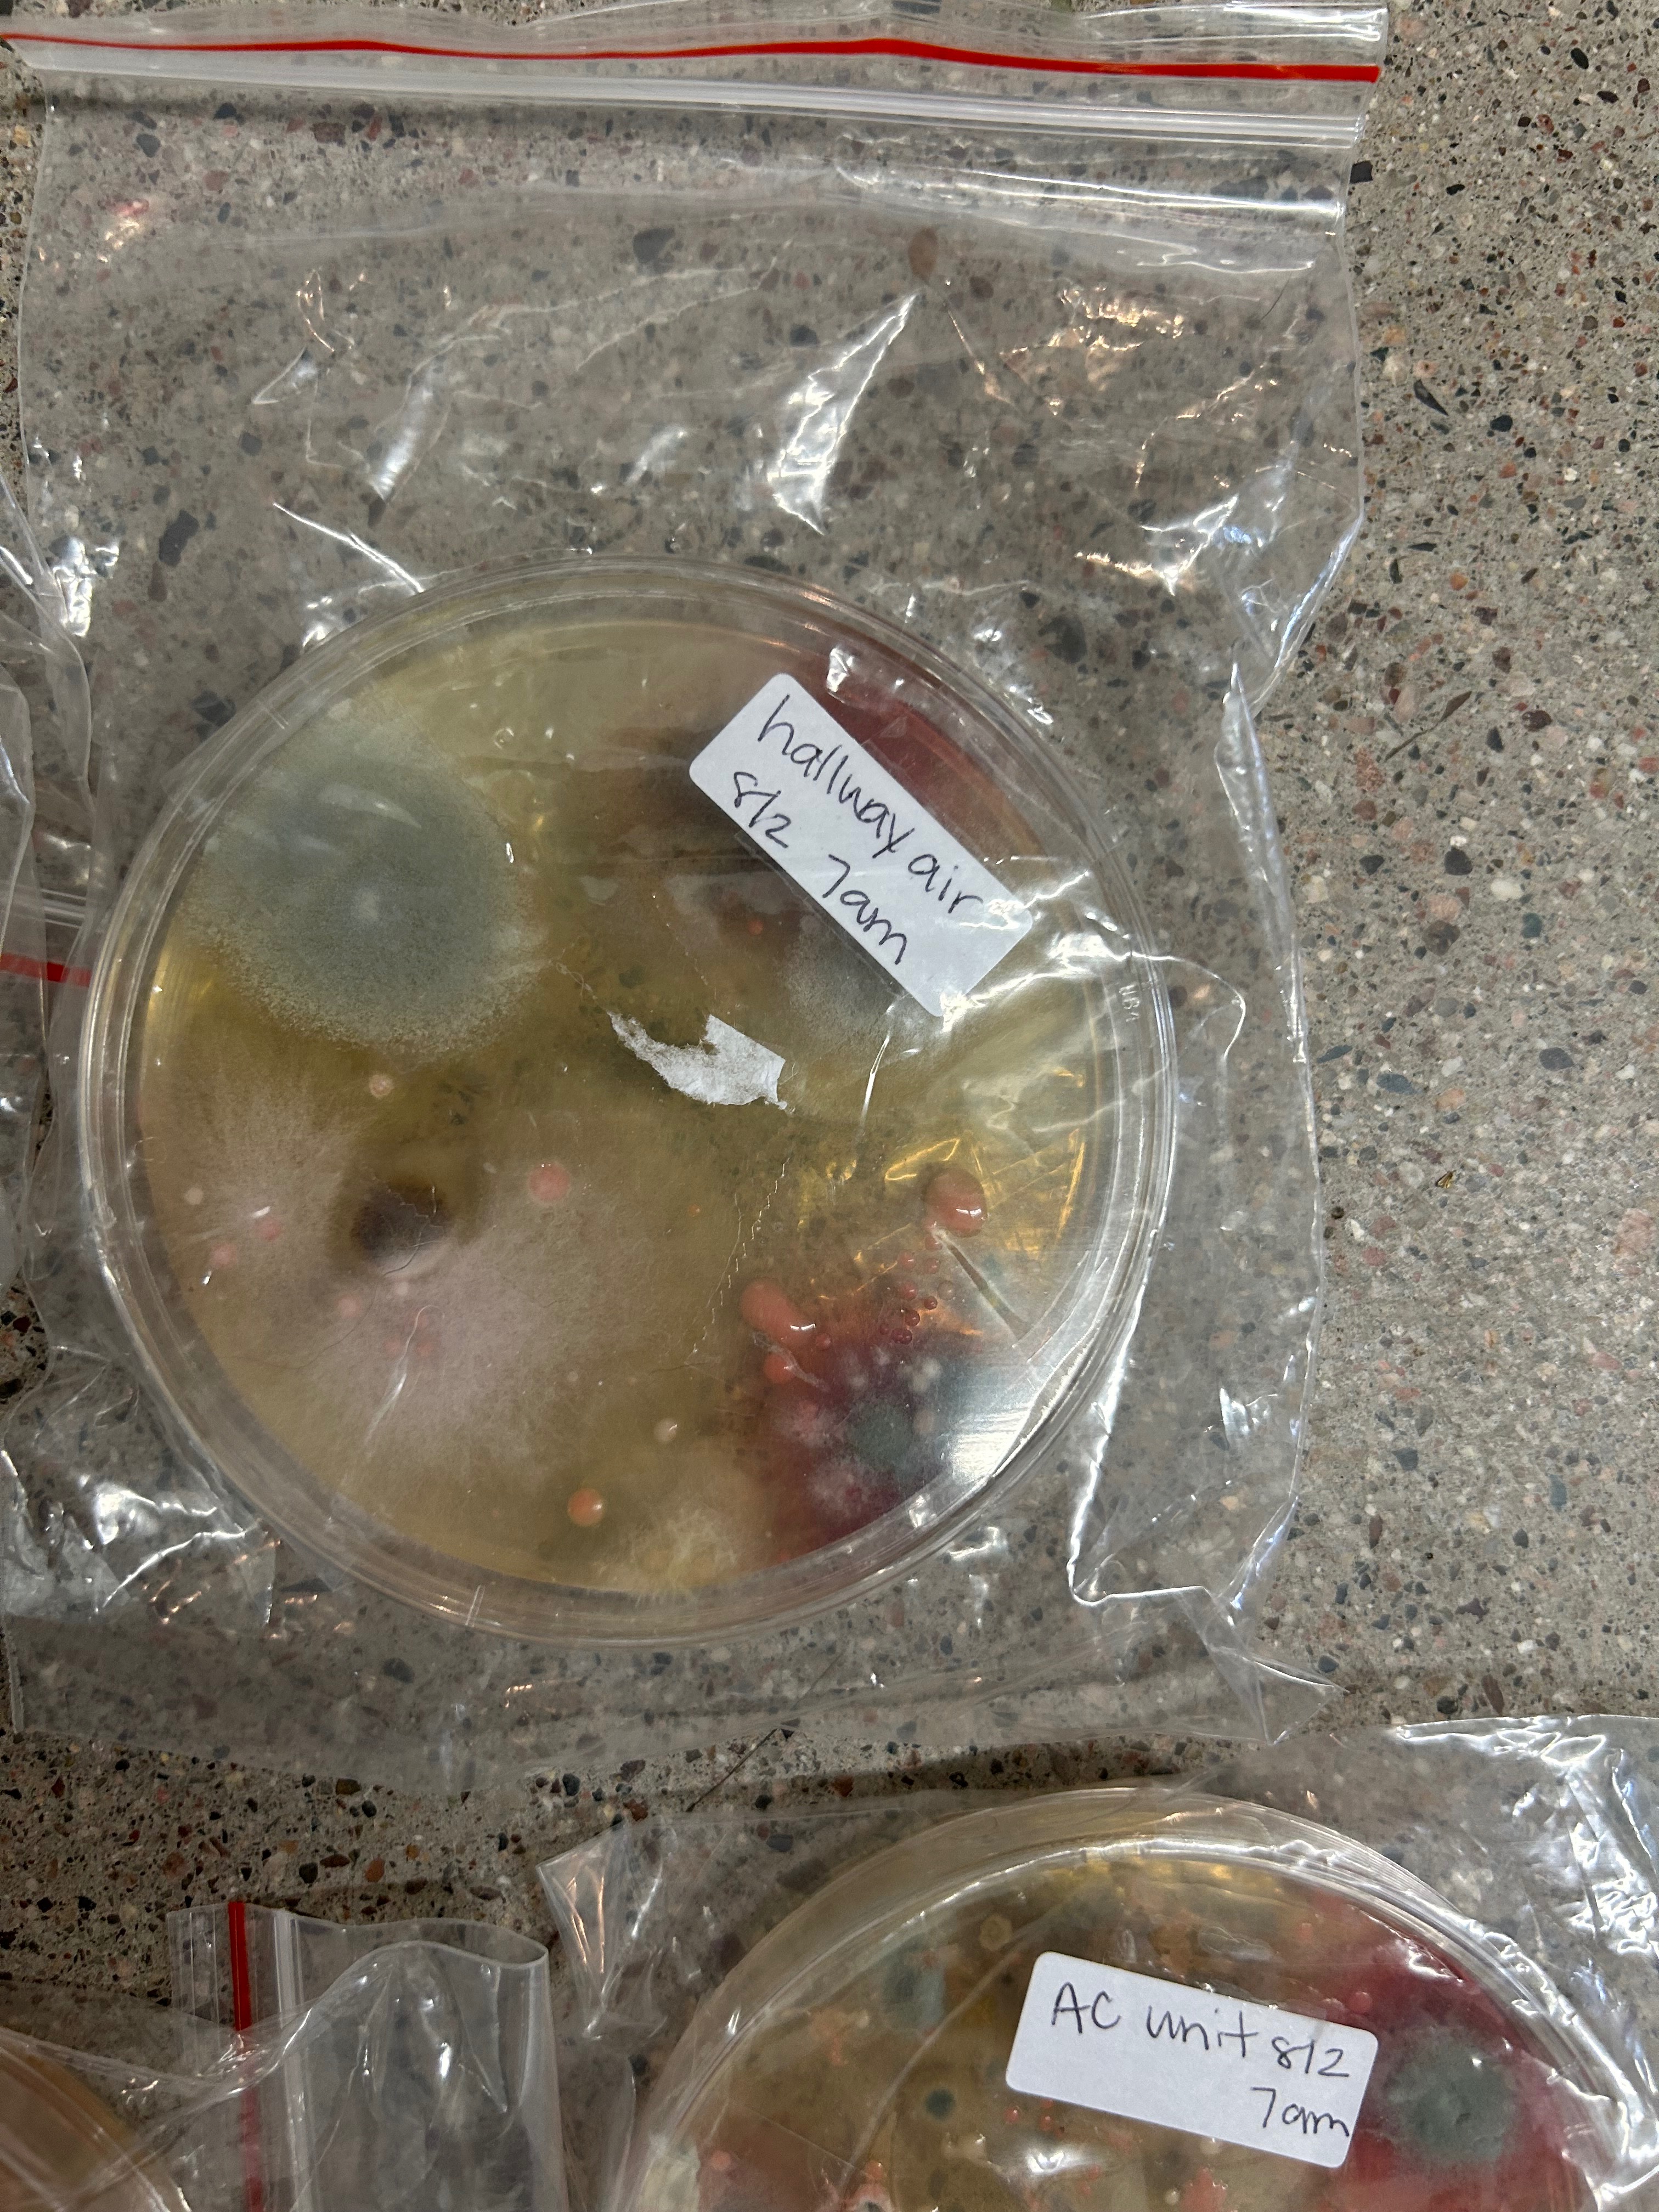

- S
- K
- L
Two months ago, the AC in my apartment began leaking heavily. Despite repeated requests for repair, tickets, calls, and emails were all left unanswered. The property management and Greystar did nothing. Over time, mold spread through the carpets and air system. My daughter and I became sick.
I was faced with an impossible choice — stay in a home making us ill, or leave with nowhere to go. I chose our health, even if it meant facing homelessness for the first time in our life.
To add salt to the wound, the complex left a 5 day notice with late fees after I refused to pay August rent and instead put that money towards temporary safe housing.
I’m currently in the process of filing legal ramifications against the property however, our temporary housing ends Thursday and beyond that, I have no answers.
If you’re unable to donate, please like my Google review to keep the pressure on the property. All documentation can be seen on the review. Nothing is too small, any donation helps with food and additional time in temporary housing.